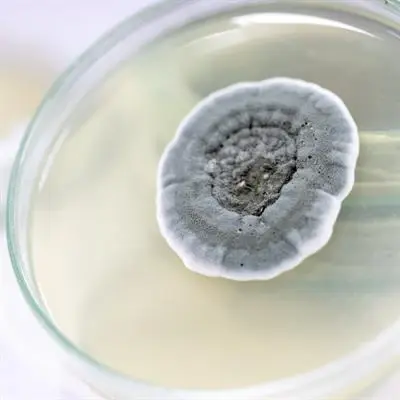

" This glossary explains common scientific terms related to fungi and biotechnology.
It is designed for students, researchers, and readers who want clear and simple definitions without needing to read complex textbooks. "
Amylase
An enzyme that converts starch into simple sugars. Widely used in food processing and fermentation.
Antifungal
A compound that prevents fungi from growing or kills fungal cells.
Aspergillus
A common mould that produces spores. Some species are useful in biotechnology, others can cause infections.
Biofuel
A renewable energy source made from biological materials, often with the help of fungal enzymes.
Biotechnology
The use of living organisms, such as fungi, to produce useful products like enzymes, proteins, or industrial compounds.

Cell Wall
The rigid structure surrounding fungal cells, giving them shape and protection.

Cellulase
An enzyme that breaks down cellulose (plant material). Used for biofuel production and industrial applications.

Chromosome
A DNA structure that contains the genetic information of fungi and other organisms.
DNA (Deoxyribonucleic Acid)
The molecule that carries genetic information in all living cells, including fungi.
Degradation
The breakdown of complex molecules (proteins, fats, sugars) by enzymes.
Enzyme
A protein that speeds up chemical reactions in cells. Fungal enzymes are used in many industries.
Eukaryote
An organism with complex cells that contain a nucleus. Fungi belong to this group.
Host
The organism (like a human or plant) that a fungus can live on or inside.
Hyphae
Thread-like filaments that make up the body of a fungus.
Metabolite
A small molecule produced during metabolism. Fungi create useful metabolites like antibiotics and acids.

Recombinant DNA
DNA created by combining genetic material from different organisms, often used in fungi for biotechnology.
A transparent fish used in research to observe fungal infections in living organisms.
A condition studied in fungi where the host reduces available zinc to block fungal growth.
Why This Glossary Matters
Fungi are incredibly diverse organisms, playing crucial roles in nature, biotechnology, and scientific research.
This glossary provides a clear overview of the main terms used to study and work with fungi, from enzymes and genetic tools to cellular structures and model organisms.
Understanding these basic concepts helps readers appreciate how fungi are both fascinating biological systems and powerful tools in biotechnology, biofuel production, industrial applications, and laboratory research.
By learning these terms, students, researchers, and curious visitors can navigate fungal biology more confidently and understand the technical language used in scientific studies and biotechnological applications.














